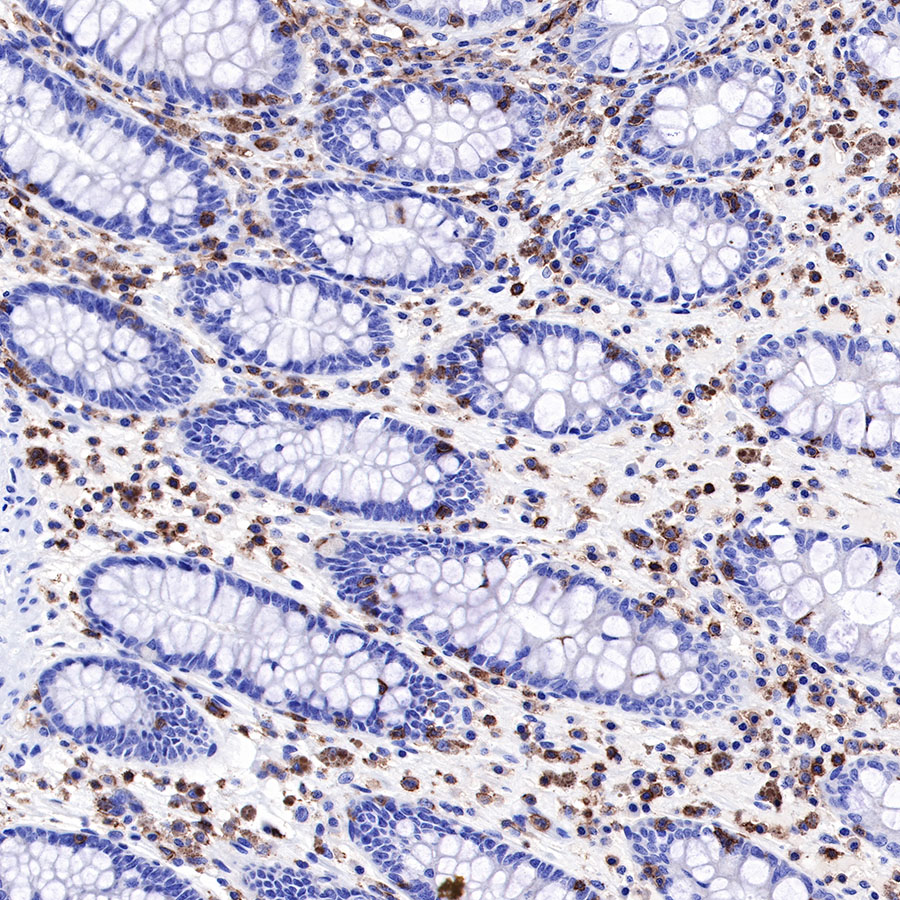
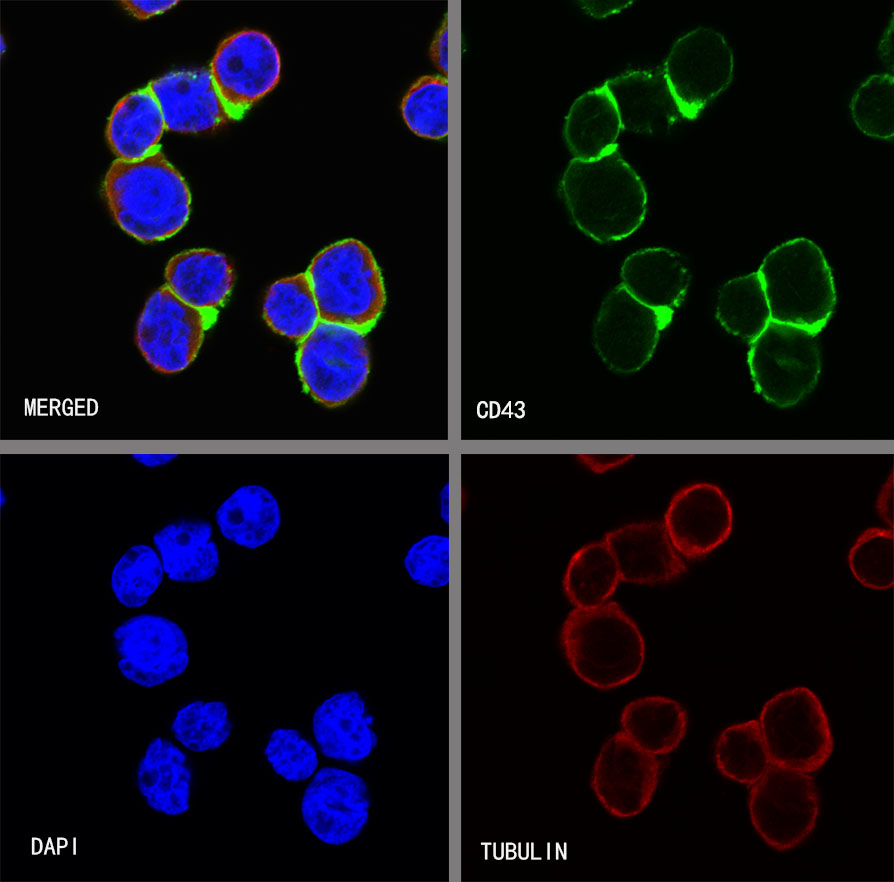

Flow cytometric analysis of 4% PFA fixed 90% methanol permeabilized Jurkat (Human T cell leukemia T lymphocyte) cells labelling CD43 antibody at 1/250 (0.1 μg) dilution / (red) compared with a Rabbit monoclonal IgG (Black) isotype control and an unlabelled control (cells without incubation with primary antibody and secondary antibody) (Blue). Goat Anti - Rabbit IgG Alexa Fluor® 488 was used as the secondary antibody.
Product Details
Product Details
Product Specification
| Host | Rabbit |
| Antigen | CD43 |
| Synonyms | Leukosialin, GPL115, GALGP, Leukocyte sialoglycoprotein, Sialophorin |
| Immunogen | N/A |
| Location | Membrane |
| Accession | P16150 |
| Clone Number | SDT-R101 |
| Antibody Type | Rabbit mAb |
| Application | IHC-P, ICC, ICFCM |
| Reactivity | Hu |
| Purification | Protein A |
| Concentration | 0.25 mg/ml |
| Physical Appearance | Liquid |
| Storage Buffer | PBS, 40% Glycerol, 0.05% BSA, 0.03% Proclin 300 |
| Stability & Storage | 12 months from date of receipt / reconstitution, -20 °C as supplied |
Dilution
| application | dilution | species |
| IHC-P | 1:1000 | null |
| ICFCM | 1:250 | null |
| ICC | 1:250 | null |
Background
CD43 (leukosialin) is a transmembrane glycoprotein expressed in a variety of hematopoietic cells, including B lymphocytes, and a variety of malignancies including lymphoma, leukemia, and solid tumors. CD43 plays an important role in the development of many diseases, and coexpression of CD43 and CD20 on peripheral B cells is a predictive factor of hematopoietic malignancy [PMID: 25682152].
Picture
Picture
FC

Immunohistochemistry

IHC shows positive staining in paraffin-embedded human mantle cell lymphoma. Anti-CD43 antibody was used at 1/1000 dilution, followed by a HRP Polymer for Mouse & Rabbit IgG (ready to use). Counterstained with hematoxylin. Heat mediated antigen retrieval with Tris/EDTA buffer pH9.0 was performed before commencing with IHC staining protocol.

IHC shows positive staining in paraffin-embedded human diffuse large B-cell lymphoma. Anti-CD43 antibody was used at 1/1000 dilution, followed by a HRP Polymer for Mouse & Rabbit IgG (ready to use). Counterstained with hematoxylin. Heat mediated antigen retrieval with Tris/EDTA buffer pH9.0 was performed before commencing with IHC staining protocol.

IHC shows positive staining in paraffin-embedded human colon cancer. Anti-CD43 antibody was used at 1/1000 dilution, followed by a HRP Polymer for Mouse & Rabbit IgG (ready to use). Counterstained with hematoxylin. Heat mediated antigen retrieval with Tris/EDTA buffer pH9.0 was performed before commencing with IHC staining protocol.

IHC shows positive staining in paraffin-embedded human endometrial cancer. Anti-CD43 antibody was used at 1/1000 dilution, followed by a HRP Polymer for Mouse & Rabbit IgG (ready to use). Counterstained with hematoxylin. Heat mediated antigen retrieval with Tris/EDTA buffer pH9.0 was performed before commencing with IHC staining protocol.
IHC shows positive staining in paraffin-embedded human colon. Anti-CD43 antibody was used at 1/1000 dilution, followed by a HRP Polymer for Mouse & Rabbit IgG (ready to use). Counterstained with hematoxylin. Heat mediated antigen retrieval with Tris/EDTA buffer pH9.0 was performed before commencing with IHC staining protocol.

IHC shows positive staining in paraffin-embedded human liver. Anti-CD43 antibody was used at 1/1000 dilution, followed by a HRP Polymer for Mouse & Rabbit IgG (ready to use). Counterstained with hematoxylin. Heat mediated antigen retrieval with Tris/EDTA buffer pH9.0 was performed before commencing with IHC staining protocol.

IHC shows positive staining in paraffin-embedded human lung. Anti-CD43 antibody was used at 1/1000 dilution, followed by a HRP Polymer for Mouse & Rabbit IgG (ready to use). Counterstained with hematoxylin. Heat mediated antigen retrieval with Tris/EDTA buffer pH9.0 was performed before commencing with IHC staining protocol.

IHC shows positive staining in paraffin-embedded human tonsil. Anti-CD43 antibody was used at 1/1000 dilution, followed by a HRP Polymer for Mouse & Rabbit IgG (ready to use). Counterstained with hematoxylin. Heat mediated antigen retrieval with Tris/EDTA buffer pH9.0 was performed before commencing with IHC staining protocol.
Immunocytochemistry
ICC shows positive staining in HL-60 cells. Anti-CD43 antibody was used at 1/250 dilution (Green) and incubated overnight at 4°C. Goat polyclonal Antibody to Rabbit IgG - H&L (Alexa Fluor® 488) was used as secondary antibody at 1/1000 dilution. The cells were fixed with 4% PFA and permeabilized with 0.1% PBS-Triton X-100. Nuclei were counterstained with DAPI (Blue). Counterstain with tubulin (red).

Negative control:ICC shows negative staining in Ramos cells. Anti-CD43 antibody was used at 1/250 dilution and incubated overnight at 4°C. Goat polyclonal Antibody to Rabbit IgG - H&L (Alexa Fluor® 488) was used as secondary antibody at 1/1000 dilution. The cells were fixed with 4% PFA and permeabilized with 0.1% PBS-Triton X-100. Nuclei were counterstained with DAPI (Blue). Counterstain with tubulin (red).
